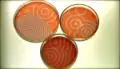

FFGR

5ο ΔΙΕΘΝΕΣ ΦΕΣΤΙΒΑΛ ΕΠΙΣΤΗΜΟΝΙΚΩΝ ΤΑΙΝΙΩΝ ΘΕΣΣΑΛΟΝΙΚΗ
DEC 2010DEC 2010
Το Διεθνές Φεστιβάλ Επιστημονικών Ταινιών υποδέχθηκε στην Αθήνα τους φίλους του, φέτος τον Οκτώβριο, στο Ινστιτούτο Θερβάντες. Μέσα σε εφτά ημέρες προβλήθηκαν ταινίες από διάφορα επιστημονικά πεδία και βραβεύτηκαν οι καλύτερες συμμετοχές από τη Διεθνή Κριτική Επιτροπή του Φεστιβάλ και από το κοινό. Μετά από πέντε συνεχείς χρονιές επιτυχημένης παρουσίας στην Αθήνα, όπου πια το Φεστιβάλ αποτελεί θεσμό, και μετά την περυσινή, πρώτη, θερμή φιλοξενία στη Θεσσαλονίκη, η διοργάνωση θα βρεθεί και πάλι στην πόλη για να παρουσιάσει τις καλύτερες ταινίες του φετινού φεστιβάλ.
Το CAID Societas Scientia et Ars – διοργανωτής του Φεστιβάλ- συστήνει ένα φεστιβάλ που συνδυάζει την τέχνη του κινηματογράφου και την επιστημονική γνώση. Όταν η βιολογία, η φυσική, η αστρονομία και τα μαθηματικά μπαίνουν στην κινηματογραφική αίθουσα και συναντούν το κοινό, με εργαλεία τελευταίας τεχνολογίας και την ιδιαίτερη ματιά ταλαντούχων σκηνοθετών, τότε η επιστήμη γίνεται ψυχαγωγία.
Η είσοδος στις προβολές είναι ελεύθερη.
Περισσότερες πληροφορίες: 210 8945945. http://isffa.blogspot.com. www.caid.gr/isffa .caidbase@otenet.gr

Σύνδεσε και Προσευχήσου
Η Ευρωπαϊκή Επιτροπή σχεδιάζει να σταματήσει την πτώση του αριθμού γεννήσεων στην ΕΕ. Πώς; Με τα ρομπότ. Σε μια τέτοια ζωή, όμως, θα υπάρχει χώρος για τον άνθρωπο; Σε αυτή την ταινία, η αμφισβήτηση της τεχνολογίας έρχεται από τους ίδιους τους δημιουργούς της (Βραβείο Επικοινωνίας της Επιστήμης)
- Δευ Δεκ 13 - 2010 19:30

Η Περιπέτεια από το Βρέφος στο Φιλί
Τα πρώτα δεκαπέντε χρόνια της ζωής μας, σε μια ταινία με εξαιρετικό αισθητικό αποτέλεσμα, εκπληκτικά μέσα απεικόνισης και πάνω απ’ όλα χιούμορ. Ψυχαγωγία και έρευνα σε τέλεια αναλογία (β' βραβείο κοινού).
- Δευ Δεκ 13 - 2010 21:15

Συνομιλίες για την Επιστήμη
Ο Γιώργος Γραμματικάκης και παγκόσμια αναγνωρισμένοι Έλληνες επιστήμονες συζητούν για τα απλά σωματίδια της ύλης, τη δομή του Σύμπαντος και το Big Bang. Εάν η κατανόηση του απείρως μεγάλου είναι, εξίσου, δύσκολη με την κατανόηση του απείρως μικρού, στο ντοκιμαντέρ αυτό, η συνομιλία τους κατορθώνει να είναι...απείρως ενδιαφέρουσα (Ειδική Διάκριση β’)
- Τρί Δεκ 14 - 2010 19:30

Ανθρώπινη Ευφυΐα
Ο ανθρώπινος εγκέφαλος μπαίνει στο μικροσκόπιο για να αναδειχθεί για, ακόμη μια φορά, η μοναδικότητά του. Με πραγματικά πειράματα θα ανακαλύψουμε πώς η φαντασία είναι αυτή που μας κάνει να διαφέρουμε από όλα τα υπόλοιπα ζώα (Ειδική Διάκριση α’)
- Τρί Δεκ 14 - 2010 20:30

Ως το Άπειρο και Ακόμα Παραπέρα
Κανείς δε θα περίμενε ότι θα γινόταν ποτέ μια υπέροχη κινηματογραφική ταινία που μιλάει για τους αριθμούς και το άπειρο. Κι όμως, οι δημιουργοί αυτής της ταινίας το έχουν καταφέρει. Μετά από αυτό το φιλμ, η ζωή σας δεν θα είναι ποτέ ξανά η ίδια. Η μαγεία των αριθμών στην αίθουσα. (Βραβείο Τέχνης)
- Τρί Δεκ 14 - 2010 21:45

Εξωγήινοι του Βυθού
Αυτή δεν είναι μονάχα μια ταινία για ένα πλάσμα της θάλασσας. Είναι μια ταινία για τον επονομαζόμενο «Χουντίνι του βυθού». Μαγικές ικανότητες που αποδίδονται με σούπερ πειράματα και εκπληκτικές υποβρύχιες λήψεις. Ιδού το χταπόδι... (Βραβείο Καινοτομίας & Τεχνολογίας)
- Τετ Δεκ 15 - 2010 19:30

Ξέρετε τι Ώρα είναι;
Εσείς, ξέρετε τι ώρα είναι; Κοιτώντας ένα ρολόι έχουμε την εντύπωση ότι γνωρίζουμε. Κι όμως, δεν υπάρχει κανένα τεράστιο ρολόι στον ουρανό που να χτυπάει με τον ίδιο ρυθμό για όλους. Μέσα από ένα ταξίδι στην αρχή του χρόνου, ανακαλύπτουμε ότι, ίσως, η εμπειρία του χρόνου είναι μία ψευδής ιδέα...για όλους μας (Βραβείο Κοινού)
- Τετ Δεκ 15 - 2010 20:30
Η Κρυφή Ζωή του Χάους
Όλοι έχουμε ακούσει ότι αν μια πεταλούδα χτυπήσει τα φτερά της στη Βραζιλία, μπορεί να προκαλέσει ανεμοστρόβιλο στο Τέξας. Κινηματογράφος για το φαινόμενο της πεταλούδας που απαντά στο «πώς βρεθήκαμε εδώ;» Το βραβείο καλύτερης ταινίας βάζει σε τάξη στη θεωρία του Χάους (Βραβείο Καλύτερης Ταινίας)
- Τετ Δεκ 15 - 2010 21:45






